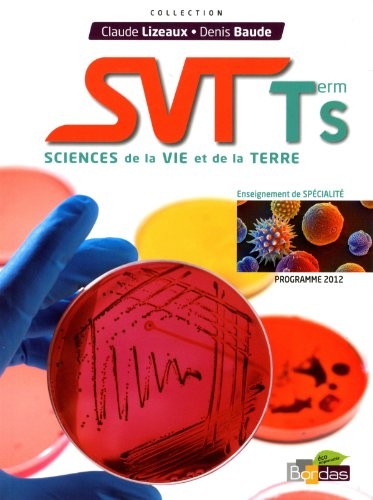
SVT term S : Sciences de la vie et de la terre (Programme 2012)

SVT term S : Sciences de la vie et de la terre (Programme 2012)
Auteur :
Editeur : Bordas ›
Adapté pour le travail en classe et en dehors des cours, ce manuel présente le cours SVT de terminale S de spécialité. Chaque chapitre propose des activités, une synthèse et des exercices corrigés. Un guide pratique en fin d'ouvrage rassemble des documents utiles pour référence et pour les activités.
23,70 €
Parution : Avril 2012
240 pages
ISBN : 978-2-0473-2930-6
Fiche consultée 26 fois